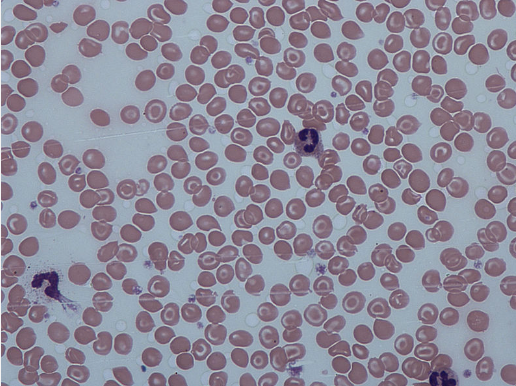
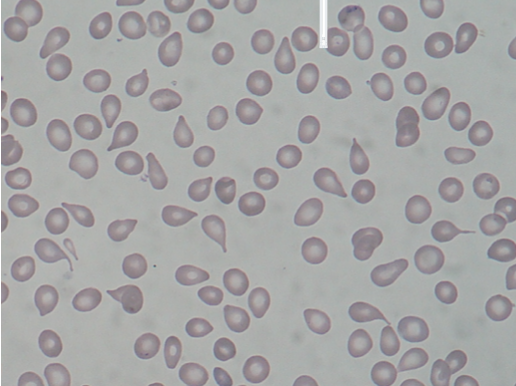
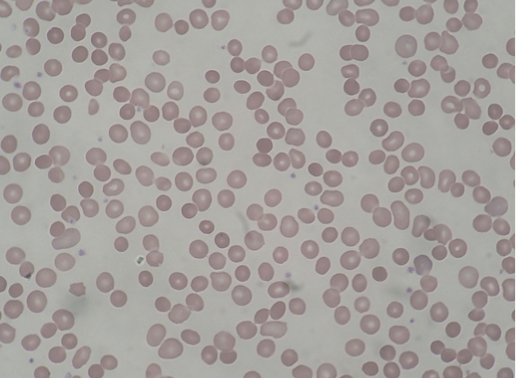
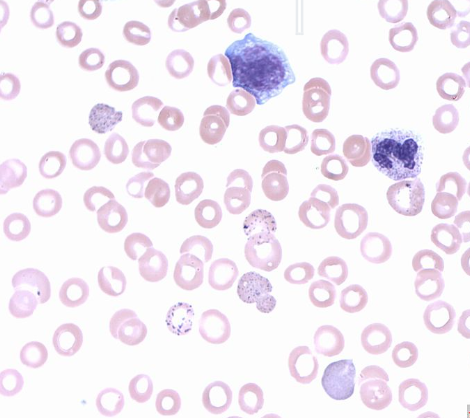
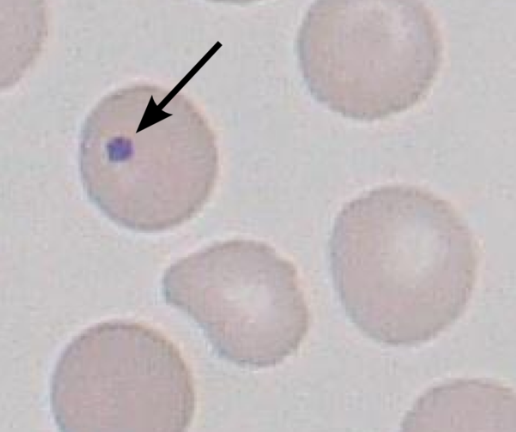
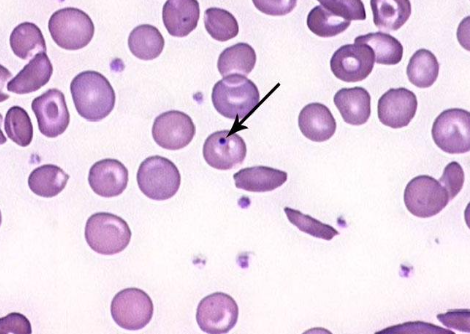
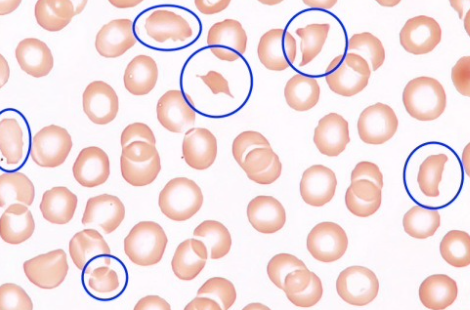
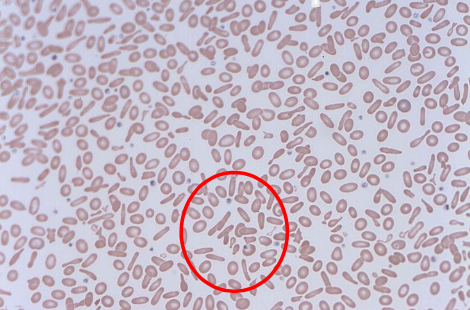
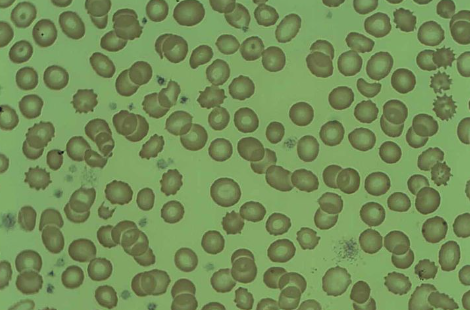

Blood Films
A blood film is the process where blood cells are taken and spread on a slide for histological analysis.
Particular conditions can lead to the presence of specific blood cells which can be seen in a blood smear
Target Cells (Mexican Hat)
These are cells which are seen in a few conditions.
They are formed due to a disproportional increase in membrane surface area to volume of haemoglobin leading to membrane excess
Associated Conditions
Sickle cell/thalassaemia
Iron-deficiency anaemia
Hyposplenism
Liver disease
‘Tear-drop’ Poikilocytes
These are red blood cells which have the shape of a tear-drop.
They are squeezed out of the bone marrow due to bone marrow infiltration in myelofibrosis.
Associated Conditions
Myelofibrosis
Spherocytes (rounded rather than donut)
These are spherical red blood cells
They are due to a a defective RBC cytoskeleton which leads to a fragile, inflexible sphere shape.
Associated Conditions
Hereditary Spherocytosis
Autoimmune haemolytic anaemia
Basophilic stippling
This occurs due to defective erythropoiesis.
Associated Conditions
Lead poisoning
Thalassaemia
Sideroblastic anaemia
Myelodysplasia
Howell-Jolly bodies
Basophilic DNA cluster due to failure of RBC to eject nuclear material. They are usually cleared by the spleen.
Associated Conditions
Hyposplenism e.g. 2nd to splenectomy, splenic infarction from sickle cell
Heinz bodies
Multiple spots of denatured haemoglobin.
Associated Conditions
G6PD deficiency
Alpha-thalassaemia
Schistocytes (‘helmet cells’)
Mechanical shearing of red blood cells.
Associated Conditions
Intravascular haemolysis
Mechanical heart valve
Disseminated intravascular coagulation
‘Pencil’ poikilocytes
The iron deficiency causes red blood cells to look like pencils.
Associated Conditions
Iron deficiency anaemia
Burr cells (echinocytes)
Due to abnormal cell membrane functioning.
Associated Conditions
Artefact due to staining
Uraemia
Pyruvate kinase deficiency
Sources
Image 1:
Dr Graham Beards, CC BY -SA 3.0 <https://creativecommons.org/licenses/by-sa/3.0>, via Wikimedia Commons
Image 2:
Paulo Henrique Orlandi Mourao, CC BY-SA 3.0 <https://creativecommons.org/licenses/by-sa/3.0>, via Wikimedia Commons
Image 3:
Prof. Erhabor Osaro, CC BY-SA 4.0 <https://creativecommons.org/licenses/by-sa/4.0>, via Wikimedia Commons
Image 4:
Paulo Henrique Orlandi Mourao and Mikael Häggström, CC BY-SA 3.0 <https://creativecommons.org/licenses/by-sa/3.0>, via Wikimedia Commons
Image 5:
Ailuromancy, Public domain, via Wikimedia Commons
Image 6:
Central Hematology Laboratory Hemostasis Research Laboratory Bern University Hospital & University of Bern, CC BY-SA 4. <https://creativecommons.org/licenses/by-sa/4.0>, via Wikimedia Commons
Image 7:
Osaretin, CC BY-SA 4.0 <https://creativecommons.org/licenses/by-sa/4.0>, via Wikimedia Commons
Disclaimer



